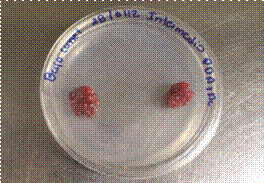

Resumen: Se realizó el aislamiento, identificación y evaluación in vitro y en campo de hongos antagonistas de Botrytis cinerea Pers., en plantaciones de mora. La obtención de organismos antagonistas se hizo en Cartago en las localidades de La Luchita, Bajo Canet, Jardín y División durante el 2012. De los frutos se obtuvo un grupo de 43 aislamientos pertenecientes a 10 géneros distintos de los hongos: Aspergillus sp., Bispora sp., Cladosporium spp., Colletotrichum sp., Curvularia sp., Macrophoma sp., Paecilomyces spp., Pestalotia spp., Rhizoctonia sp., y Trichoderma spp. A todos los aislamientos se les realizaron pruebas de capacidad antagónica, mediante la técnica de cultivos duales, competencia por sustrato y antibiosis. Se seleccionaron solamente los aislamientos que superaron un 70% del PIC, y estos fueron 4 aislamientos (BC1, J14, J2.2 y J2.1) del género Trichoderma spp. Para las pruebas de campo se utilizaron 3 aislamientos (BC1, J2.2 y J2.1) del presente trabajo y 3 (BV1, SM13B y SM18) del mismo género previamente aislados. Las pruebas de campo se realizaron en el 2013. Los aislamientos de Trichoderma spp., que tuvieron estadísticamente (p≤0,0001) mayor efecto sobre B. cinerea fueron BV1 y BC1, los cuales dieron menos frutos enfermos.
Palabras clave: AislamientosAislamientos,parasitismoparasitismo,Rubus sp.Rubus sp.,hongos antagonistashongos antagonistas,Botrytis cinerea.Botrytis cinerea..
Abstract: Isolation, identification, in vitro and field evaluation of antagonistic fungi of Botrytis cinerea was conducted on blackberry plantations. Collection of antagonistic organisms was carried out in Cartago in the towns of La Luchita, Bajo Canet, Garden and Division during 2012. From the fruits, a group of 43 isolates belonging to 10 different fungi genera were obtained: Aspergillus sp., Bispora sp., Cladosporium spp., Colletotrichum sp., Curvularia sp., Macrophoma sp., Paecilomyces spp., Pestalotia spp., Rhizoctonia sp., and Trichoderma spp. All isolates were tested for antagonistic capacity by dual culture technique, substrate competition and antibiosis. Only isolates that exceeded 70% of the PGI were selected, and these were 4 isolates (BC1, J14, J2.2 and J2.1) of the genus Trichoderma spp. Field tests were done by using 3 isolates (BC1, J2.2 and J2.1) from the present work and 3 (BV1, SM13B and SM18) of the same genus from a previous work. Field trials were carried out in 2013. Trichoderma spp. isolates which had statistically (p≤0.0001) greater effect on Botrytis cinerea were BV1 and BC1, showing less affected fruits.
Keywords: Isolations, parasitism, Rubus sp., antagonists fungi, Botrytis cinerea..
Artículo
Evaluación de Hongos Antagonistas DeBotrytis cinereaPers., en Plantaciones de Mora, Costa Rica1
Evaluation of Botrytis cinerea Pers., antagonist fungi in blackberry plantations of Costa Rica
Recepción: 23 Agosto 2016
Aprobación: 18 Enero 2017
En los últimos años, la mora se ha visto afectada por problemas fitosanitarios que disminuyen su rendimiento; entre ellos se encuentra la pudrición del fruto o moho gris, ocasionado por el hongo Botrytis cinerea Pers. Esta enfermedad perjudica de forma relevante en el cultivo, pues necrosa los tallos, momifica, pudre y descompone los frutos maduros e inmaduros. Este patógeno infecta más de 200 especies vegetales distintas, en las cuales causa serias pérdidas económicas antes y después de la recolección (Jarvis 1977). El hongo infecta las flores en campo, permanece latente dentro de sus estructuras y finalmente se desarrolla con agresividad en los frutos tanto en campo como en poscosecha.
Tradicionalmente el principal método de combate de B. cinerea ha sido el uso de fungicidas. Sin embargo, aunque son el principal soporte en el manejo del moho gris, recientes estudios han evidenciado una menor efectividad en las aplicaciones, producto del abrupto aumento de los niveles de tolerancia del patógeno a fungicidas, por el uso repetitivo de ellos (Esterio y Auger 1997, Ferreira 1989, Zhang et al. 1994).
Por otra parte, el consumidor ha tomado conciencia de los riesgos a que se expone debido a los residuos de fungicidas en el follaje y frutos, lo cual causa un creciente rechazo al uso de productos sintéticos dañinos para la salud humana y el ambiente. En respuesta a esta situación se han establecido restricciones al uso de plaguicidas y se han incentivado investigaciones orientadas a proporcionar nuevas opciones de combate que disminuyan los residuos de agroquímicos, junto con medidas de manejo cultural y biológico (Zhang et al. 1994). Una opción para combatir el moho gris en el cultivo de la mora, es el empleo de organismos antagonistas, que puedan ser usados en el manejo de esta enfermedad, sin causar daños al ambiente o la salud de los consumidores.
En este sentido se plantea esta investigación que pretende buscar antagonistas nativos en las zonas donde se cultiva la mora, para evaluar su potencial como biocontroladores y de esta forma contribuir a la sostenibilidad agrícola de las pequeñas unidades dedicadas al cultivo de la mora.
Este trabajo se realizó en diferentes plantaciones de mora orgánica localizadas en las 4 principales zonas productoras de Costa Rica: División y Jardín, en la provincia de San José, La Luchita del Guarco y Bajo Canet, provincia de Cartago. Las principales características de esas localidades se muestran en el Cuadro 1.
Los respectivos aislamientos de hongos antagonistas y las pruebas in vitro se llevaron a cabo en el Laboratorio de Fitopatología de la Universidad Nacional de Costa Rica, durante el primer semestre 2013. Las fincas que se seleccionaron fueron pequeñas unidades productivas de cultivo orgánico.

En cada una de las localidades seleccionadas se tomaron 10 frutos de mora en 3 diferentes estados fenológicos de desarrollo: maduros, intermedios, recién cuajados y secos, como lo muestra la Figura 1.

La selección de frutos se hizo al azar y se realizaron 2 muestreos en cada parcela con un lapso de tiempo de 2 semanas entre un muestreo y el siguiente. Se tomó una finca por lugar y en cada una se hizo 2 visitas. Se seleccionaron varias unidades productivas con el fin de conocer eventuales variaciones en la población de antagonistas influenciada por factores ecológicos. Los frutos se tomaron en diferentes puntos de la planta: parte baja, media o alta. Una vez que se obtuvo el material se transportó en bolsas plásticas con su debida identificación y se depositó dentro de una hielera para disminuir o evitar la deshidratación de los frutos. Luego el material se trasladó al Laboratorio de Fitopatología de la Universidad Nacional para su respectivo análisis.
Los frutos seleccionados de cada una de las categorías antes señaladas, se cultivaron directamente en placas Petri con PDA+ ácido láctico, sin desinfectarse ni dividirse. Cada plato tuvo únicamente 2 frutos en su superficie ubicados en puntos extremos (como se indica en la Figura 2), con 10 repeticiones para cada fase de fruto y visita.

Estos se incubaron por 8 días en la oscuridad y de las diferentes colonias obtenidas se hizo una réplica en platos Petri, con el mismo medio, para luego purificarse hasta obtener cultivos puros. De cada cultivo se hicieron 3 réplicas.
Dos de los platos se guardaron temporalmente como respaldo (refrigerado a 10ºC) y el otro se usó para hacer la respectiva identificación. Los hongos obtenidos de esta forma, fueron identificados con base en rasgos morfológicos principalmente con las claves para Deuteromycota (Ellis 1971, Barnett y Hunter 1998) y Ascomycota (Hanlin 1997).
Esto se hizo mediante montajes para microscopía de luz con lactofenol azul como colorante.
La evaluación de la capacidad antagónica in vitro se efectuó por medio de la técnica de cultivos duales, la cual consiste en colocar en un extremo de la caja Petri un disco de 5 mm de diámetro del antagonista crecido en el medio y en el otro extremo de la caja un disco igual al anterior, pero con el agente fitopatógeno. En estas pruebas se evaluó la capacidad de competencia por sustrato y el efecto antibiótico. Para cuantificar la capacidad de competencia por sustrato se utilizaron 3 criterios:
Ubicación en la escala de clases de 5 grados planteada por Bell et al. (1982). En la primera el antagonista llega a ocupar completamente la superficie del medio de cultivo, en la segunda el antagonista llega a sobrecrecer (sobrepasar) las 2 terceras partes de la superficie del medio de cultivo. En la tercera el antagonista y el patógeno colonizan cada uno aproximadamente la mitad de la superficie y ningún organismo parece dominar al otro, en la cuarta el patógeno sobrepasa el crecimiento del antagonista colonizando 3 cuartas partes de la caja Petri y en la quinta el fitopatógeno llega a cubrir totalmente el plato Petri. La evaluación final se realizó a los 7 días después de cultivados los platos.
Lapso de tiempo (días) en el cual las cepas de antagonista y fitopatógeno entran en contacto. Para medir la velocidad de colonización del posible antagonista.
Crecimiento radial (CR) de las cepas expresado en centímetros (cm) para determinar el grado de colonización y crecimiento de estas.
Para evaluar el efecto antibiótico del antagonista se midió el porcentaje de inhibición del crecimiento (PIC): Se calculó mediante la fórmula utilizada por Skidmore y Dickinson (1976), Royse y Ries (1978).
Se utilizó un diseño completamente al azar con 4 repeticiones por tratamiento. La unidad experimental consistió en una caja Petri de 9,0 cm de diámetro. Los resultados obtenidos en el experimento (PIC y CR) se analizaron mediante un análisis de varianza (ANOVA) (p<0,05) y comparación de medias de Tukey para determinar diferencias significativas entre tratamientos. Se utilizó el programa estadístico SAS 9.1.
Como resultado de todo el trabajo anterior, se escogieron 3 de los mejores aislamientos, para hacer las pruebas de campo. Debido a que fue Trichoderma spp., el antagonista más promisorio se decidió usar los mejores 3 de este trabajo y 3 de los aislamientos más eficientes, obtenidos por Calvo (2012).
Previo a la prueba, se prepararon los cultivos puros de las cepas seleccionadas, para utilizarlas en la preparación de matrices en botellas de vidrio estériles, con arroz como sustrato, según lo propuso Mata (2005). Luego, con su contenido se preparó una suspensión madre de conidios con Tween 80 como dispersante, para cada uno de los antagonistas escogidos. De la suspensión se tomaron alícuotas de 15 ml para inocular bolsas de polipropileno, previamente autoclavadas y preparadas con arroz como sustrato.
El procedimiento se hizo también con la metodología usada por Mata (2005). Las bolsas con el cultivo puro de cada antagonista, debidamente esporuladas, se usaron para preparar suspensiones de 1 X 106 conidios por mililitro, por medio de un hematocímetro y el sistema de conteo y calibración descrito por French y Herbert (1982).
Las pruebas de campo se hicieron en La Luchita del Guarco, donde se escogieron 10 racimos florales por planta para cada uno de los organismos seleccionados, a cada racimo se le eliminaron los frutos formados, para dejar solo los recién cuajados y flores en botón. Una vez listos se les aplicó 10 ml de las respectivas suspensiones, con un atomizador manual. Para realizar estas pruebas se usaron plantas ubicadas en diferentes puntos de la plantación con el fin de evitar la contaminación por deriva. Cada racimo se protegió con una redecilla para evitar los daños de insectos y aves. Veinte días después, cuando el fruto ya estaba bien desarrollado, se hizo una segunda aplicación, con los respectivos organismos y con la concentración de conidios antes indicada. Igualmente como testigos se escogieron 10 racimos florales con todo y pedúnculo a los cuales no se les aplicó nada.
En todos los casos cuando los frutos mostraron los primeros indicios de maduración se llevaron al laboratorio de Fitopatología, donde se incubaron en cámara húmeda por 10 días a 25ºC y se hizo la evaluación definitiva. En ella se estableció el número de frutos sanos, el de los afectados por B. cinerea y cantidad de frutos donde Trichoderma spp., produjo abundantes esporas.
Se utilizó un diseño completamente al azar con 10 repeticiones por tratamiento. La unidad experimental consistió en un racimo de frutos recién cuajados con sus flores en botón seleccionada de una planta al azar de la plantación. En la escogencia de las plantas se buscó la mayor homogeneidad posible de factores como tamaño, vigor, color y variedad.
El porcentaje de frutos sanos se sometió a un análisis de varianza (ANDEVA), para determinar diferencias entre tratamientos, en aquellos casos donde los hubo, se realizó una comparación de medias de tratamientos mediante la prueba de Tukey. Los supuestos del ANDEVA se comprobaron antes de proceder con los análisis para verificar o no la necesidad de transformar los datos previos al ANDEVA. Se utilizó el programa estadístico SAS.
La búsqueda de posibles antagonistas asociados a frutos de mora dio como resultado, 43 aislamientos pertenecientes a 10 géneros distintos de hongos y un actiomycete, como se muestra en el Cuadro 2. En un estudio similar realizado por Calvo (2012) en localidades cercanas a las incluidas en el presente trabajo hay coincidencia en los géneros: Aspergillus sp., Cladosporium sp., Colletotrichum sp., Pestalotia sp., y Trichoderma sp. Sin embargo, ese mismo autor hace mención de otros hongos como: Penicillium sp., Fusarium sp., Gonatobotryum sp., que no fueron hallados en esta investigación, la cual además dio como resultado 4 organismos no determinados por Calvo (2012). Estos organismos son: un actinomicete y hongos de los géneros Bispora sp., Curvularia sp., Macrophoma sp., y Rhizoctonia sp. A pesar de que hubo una coincidencia parcial, el panorama generado por ambos trabajos pone en evidencia la diversidad de microorganismos que acompañan el fruto de mora ya sea en el carpoplano o entre las drupas. Estos espacios son ricos en secreciones de la planta y otras sustancias de origen exógeno, lo cual según Arauz (1998) propicia el crecimiento de agentes biocontroladores y patógenos en la etapa de crecimiento epifítico propio de esos organismos.
En el Cuadro 2 se destaca la mayor cantidad de hongos aislados en La Luchita donde predominaron los géneros Cladosporium sp., y Paecilomyces sp., mencionados en Arauz 1998 y Vázquez 2002 como biocontroladores de otros organismos. Paecilomyces spp., es parásito de nematodos, especialmente de huevos y quistes; también actúa como entomopatógeno de Bemicia tabaci. El género Cladosporium, por su parte, es un enemigo natural de las escamas. En el mismo cuadro también se observa la presencia de Trichoderma spp., en Bajo Canet y Jardín, hongo que como se discutirá más adelante, posee amplia acción antagonista.

En la investigación realizada por Calvo (2012) se indica la presencia de Cladosporium sp., Colletotrichum sp., Pestalotia sp., y Trichoderma sp., en La Luchita, mientras que en la presente investigación se obtuvo resultados diferentes, en ese mismo lugar, y no se obtuvo ningún aislamiento de Trichoderma sp., lo cual era de esperar, pues en 2 momentos distintos de muestreo es difícil obtener resultados idénticos, a menos que un organismo mantenga una alta población de forma sostenida a través del tiempo.
Una vez obtenida la población de organismos antes señalada y con el fin de poder seleccionar aquellos hongos con potencial antagonista, se realizaron cultivos duales. Estos fueron entre B. cinerea y cada uno de los aislamientos, evaluándose el porcentaje de inhibición de crecimiento (PIC). Los resultados de esta prueba se indican en el Cuadro 3 donde los valores promedio de todos los aislamientos de Trichoderma spp., superaron de forma clara y contundente a todos los demás, por lo que se seleccionaron solo las mejores cepas de este hongo, descartándose los otros hongos, dada la baja capacidad antagónica mostrada con esta prueba. El grupo de organismos descartados en esta etapa de la investigación, puede que tengan cualidades antagónicas contra B. cinerea.

Sin embargo, la metodología usada en este caso, no permite detectar otras propiedades antagónicas como producción de metabolitos secundarios o parasitismo de hifas que según Baker y Cook (1982) se presentan en varios hongos, pero para poder evidenciar su efecto se requiere del uso de otras metodologías más complejas, no incluidas en la presente investigación.
En total se obtuvieron 9 aislamientos de Trichoderma spp., con un valor promedio de PIC de 70%, por lo que se requirió comprobar su eficiencia antes de utilizarlos en la siguiente fase de estudio. Se procedió a hacer las respectivas pruebas, para cada uno de los aislamientos de Trichoderma spp. Los resultados de tal procedimiento se indican en el Cuadro 4, ubicándose la mayoría de estos aislamientos en las categorías I y II, según la escala utilizada.

El antagonismo de este hongo respecto a B. cinerea se estableció mediante la evaluación de la competencia por sustrato, antibiosis y el crecimiento radial. Como pudo apreciarse en el cuadro anterior los hongos J 2.1 y J 14 (clase I), J 2.2, BC1, J 13, LL y R (clase II), califican como muy eficientes en cuanto a capacidad de competencia respecto al patógeno, de conformidad con lo que señala Bell et al. 1982.
Con respecto al análisis de crecimiento radial de los antagonistas, se observó que J 21 y J 14 fueron los que permitieron un menor crecimiento (Figura 3). En los tratamientos BC1 y J 22 se observó un mayor crecimiento del patógeno en relación con las otras 2 cepas de Trichoderma spp. Los tratamientos que mostraron más eficiencia a nivel de laboratorio contra B. cinerea fueron J 21 y J 14, al limitar el crecimiento del patógeno de una forma más evidente. El resultado obtenido podría atribuirse a la acción combinada ejercida por Trichoderma sobre los patógenos, mediante la competencia por nutrientes, producción de metabolitos antifúngicos, enzimas hidrolíticas, y micoparasitismo (Stefanova et al. 1999). La antibiosis en Trichoderma spp., se efectúa por la producción de enzimas hidrolíticas y por metabolitos secundarios volátiles o no. Además las enzimas hidrolíticas son factores importantes que facilitan la competencia por sustrato y el ataque directo a un amplio ámbito de hongos patógenos de plantas (Jensen y Wolffhechel 1995).

La capacidad antagónica de los aislamientos por antibiosis se expresó por medio del porcentaje de inhibición del crecimiento (% PIC). En la Figura 4 se muestran los valores obtenidos para Trichoderma sp., sobre B. cinerea. En esta figura se aprecia que no hay diferencias estadísticas entre ellos (p<0,05), a pesar de que el aislamiento proveniente de la localidad de Jardín (J14) presentó valores de PIC, de 81,9%. En este caso algunos de los diversos mecanismos de antibiosis propios de este género, actuaron por igual en todos los casos. Tales mecanismos son según Dubos (1987), sustancias antibióticas o metabolitos que inhiben la actividad parasítica de los patógenos.
Los metabolitos usualmente involucrados, según hallazgos de otras investigaciones son: viridina, trichodermina, glioviridina, gliotoxina y harzaniolidina (Lumsden et al. 1992). De todas estas micotoxinas la más representativa es trichodermina cuya función inhibe la actividad ribosomal de los patógenos y por lo tanto su reproducción (Ghisalberti y Sivasithamparam 1991). En investigaciones de laboratorio donde se utilizó Trichoderma sp., como antagonista, se observaron zonas de inhibición de crecimiento de B. cinerea, lo cual se atribuye al efecto de los antibioticos sobre los hongos fitopatógenos (Seddik et al. 2012, Schirmbock et al. 1994). El efecto inhibitorio del crecimiento de Botrytis se ha atribuido a algunos compuestos que pueden impedir la germinación de conidios, como las tricozianinas A1 y B1 y la gliotoxina producidas por especies de Trichoderma (Di Pietro et al. 1993, Schimbock et al. 1994 citados por Elad 1996). También se atribuye este efecto a enzimas que interfieren con el desarrollo del patógeno porque degradan componentes estructurales de la pared celular, como las quitinasas, exo-y endoglucanasas y proteasas principalmente producidas por T. harzianum (Elad y Kapat 1999, Ait-Lahsen et al. 2001).

El total de aislamientos de Trichoderma spp., para las pruebas de campo fueron 7, según se indica en el Cuadro 5. De los mejores aislamientos obtenidos en el presente trabajo, se escogieron los aislamientos J 21, J 22, J14 y BC1. Sin embargo, debido a que cuando el experimento estaba establecido en campo, el productor podó severamente las plantas donde se había aplicado el aislamiento J14, fue necesario eliminar este tratamiento, razón por la cual solo quedaron 6.

Los frutos traídos de campo fueron analizados después de 10 días de estar en cámara húmeda, lugar en el cual tanto el patógeno como el antagonista, contaban con las condiciones óptimas para manifestarse. Dado que Trichoderma spp., posee diversos mecanismos por medio de los cuales reduce el crecimiento de los patógenos. Se contabilizaron los frutos aparentemente libres de crecimiento fungoso y aquellos con crecimiento de Trichoderma, en una sola categoría, resultados que se presentan en la Figura 5. En ella se aprecia que los aislamientos BV1 y BC1 son estadísticamente diferentes al testigo, por lo que se observa un efecto de los aislamientos usados sobre el crecimiento de Botrytis. Esto sugiere que los antagonistas sobrevivieron y actuaron a pesar de haberse expuesto a alta radiación solar y desecación en la superficie de los frutos. Al comparar los 2 aislamientos, puede observarse que también son diferentes entre sí, lo cual pone en evidencia que el aislamiento BV1 fue el mejor pues superó al BC1.

El aislamiento BV1 era procedente de Buena Vista de Pérez Zeledón y el BC1 de Bajo Canet, 2 sitios con condiciones ecológicas diferentes; pero a pesar de eso, conservaron sus características antagónicas en la localidad donde se llevó a cabo el experimento. También es importante destacar que BC1 en las pruebas de laboratorio mantuvo una acción antagónica moderada sobre el patógeno, pero en campo fue el que manifestó el mejor desempeño.
El efecto observado cuando se usó BV1 y BC1 podría atribuirse a que estos aislamientos fueron capaces de colonizar las flores y a su vez desplazaron a B. cinerea de su habitual sitio de infección por competencia y eventualmente también por la producción de enzimas capaces de degradar las paredes celulares del patógeno, como lo sugiere Chet (1987). La aplicación temprana sobre flores y frutos recién cuajados que se usó en este estudio quizá tuvo un efecto similar al indicado por varios autores (Dubos et al. 1983, Sutton y Perg 1993) en cultivos como vid y fresa. De manera similar, Trichoderma spp., ha actuado como antagonista contra patógenos de partes aéreas y particularmente de B. cinerea al aplicarse durante la floración de manzanos, cerezos, viñedos, tomate y pepino (O’Nelly et al. 1996, Wilson 1997).
En la Figura 6 se observan los frutos infectados solo por B. cinerea y contabilizados a los 10 días de estar en cámara húmeda. Al comparar el testigo con los aislamientos BV1 y BC1, se observa que la cantidad de frutos infectados es estadísticamente inferior al testigo, mientras los aislamientos J22 y SM13B superaron al testigo. En esos casos hubo alguna condición favorable para el establecimiento del patógeno. Aunque no hay referencias respecto a esto, una posible explicación para este resultado, es que los aislamientos de Trichoderma sucumbieran más rápido que los otros por efectos ambientales y que el inóculo natural se viera favorecido por el uso del dispersante - adherente (NP-7, ia: alquilanil oliclicoleter ®) pues fue lo único diferente usado al momento de la inoculación, mientras que en los testigos la infección observada fue solo resultado del establecimiento natural del patógeno, en ausencia de ese posible beneficio.

*Autor para correspondencia. Correo electrónico: rafael.orozco.rodriguez@una.cr